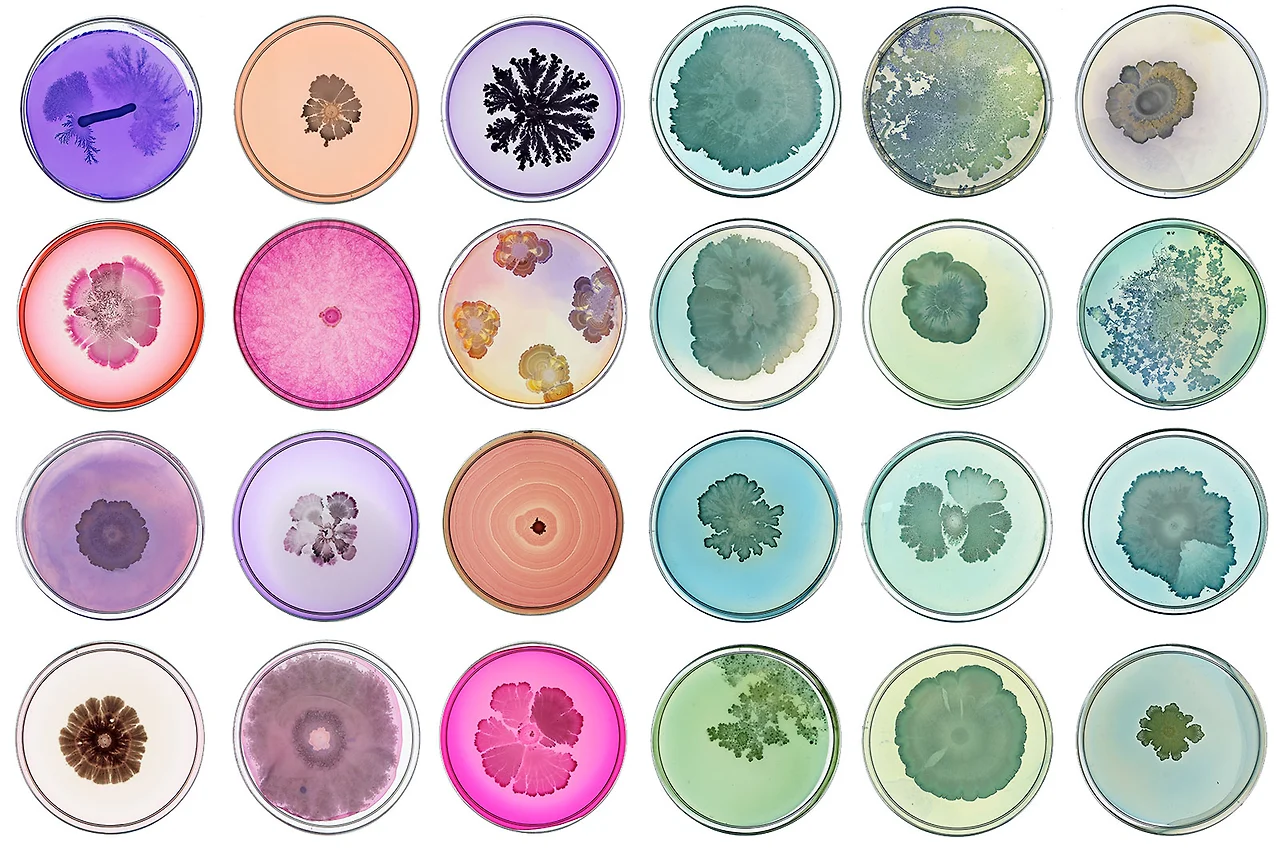

2021년 뷰티 트렌드 한 판 정리
#1.(2).3) NEXT TREND : Wellness
CONTENTS
1. WHO?
2. NEXT TREND : Wellness
Keyword : Ingredients, Natural, Inner beauty, Spirtual
WHO?
- 화장품 산업 트렌드에 대해 궁금한 취업준비생과 업계 종사자
- 이종산업에 계시면서 화장품 업계가 궁금하신 분들
SUMMARY
- 코로나와 소비자 윤리의식의 확산으로 착한 성분, 지속가능성을 위해 Wellness 트렌드 등장했습니다.
- 웰빙에 대한 키워드(미생물, 비건, 이너뷰티 등)를 통해 브랜드와 제품을 만들 때 적용해봅니다.
(1) Microbial Beauty = Probiotic Beauty
 @magazine.columbia.edu/article/miraculous-beauty-and-healing-power-ordinary-bacteria
@magazine.columbia.edu/article/miraculous-beauty-and-healing-power-ordinary-bacteria각종 화학약품, 유해환경으로 인해 감소한 장내 세균을 되살려주는 고농축 유익균을 적용한 뷰티 트렌드를 주목해보려고 합니다. 코로나 19로 인해 '면역력'에 대한 키워드가 화두입니다. 유익한 장내 미생물(Gut microbiome)을 증폭시켜 이너뷰티를 넘어선 토털 ‘Wellness’ 추구하려는 흐름이 보입니다. 안티 바이오틱스는 미생물에 의하여 만들어진 물질로 다른 미생물의 성장을 막습니다. 대표적으로 '페니실린'과 같은 항생제인데 전염병으로부터 인류를 구원했지만, 그로 인한 폐해도 큽니다. 외부의 자극(항생제)을 사용하기보다, 오히려 장내 미생물을 이용하는 형태로 관점을 바꿨습니다. 장내 미생물은 인간 체내 공존하는 미생물의 유전정보 전체를 일컫는 용어로, 인간의 모든 건강과 연결되어있습니다. 단순 질병을 넘어 스트레스 및 우울 등 신경성 질환과 뇌 관련 질환까지도 연관되어 있습니다. 종류로는 프로바이오틱스와 프리바이오틱스가 있습니다. 발효식품에 프로바이오틱스가 가장 대중적인데, 좋은 박테리아라고 보면 되고, 프리바이오틱스는 프로바이오틱스를 증폭시키는 물질입니다.
 @gallinee
@gallinee이 트렌드를 반영해서 나온 브랜드는 'gallinee'라는 브랜드를 소개합니다. 여드름, 아토피 등 피부질환 분야와 접목시킨 스킨케어 브랜드로 세포라에서 만날 수 있습니다. 기술적인 접근과 감각적이고 트렌디한 패키징(Packaging)이 특징입니다. 또 앞에서 말한 프로바이오틱스와 프리바이오틱스(Probiotics & prebiotics) 모두 적용한 특허기술 제품을 출시했습니다. 건강한 피부를 위한 스킨케어 브랜드로 'Happy microbiome, happy skin! Bring your skin to life!'로 커뮤니케이션하고 있습니다.
(2) Veganism = Vegetairan + Beginnig + ism
비건이란, 엄격한 채식주의자로 고기는 물론 우유나 달걀도 먹지 않고 실크나 가죽같이 동물에게서 원료를 얻는 제품을 사용하지 않는 사람들을 일컫습니다. 단순히 동물성 제품을 섭취하지 않는 식습관을 넘어, 동물성 제품 사용 등까지 기피하는 적극적인 의미의 비건 뷰티가 화두가 되고 있습니다. #비건뷰티(#Veganbeauty) 키워드는 상당히 진보된 미의식을 이야기합니다. 동물 원료, 동물 유래 원료, GMO(유전자 변형 생물체, Genetically Modified Organism) 원료가 일체 들어가지 않아야 하고, 동물실험을 하지 않는 것을 기조로 하고 있습니다.
 @각 업체 사이트에서 앰블럼 캡처
@각 업체 사이트에서 앰블럼 캡처비건의 인증기관은 크게 3곳이 있습니다. 영국의 ‘비건 액션(Vegan Action)’과 ‘비건 소사이어티(Vegan Society)’, 미국의 PETA가 있습니다. 비건 액션(Vegan Action)은 동물학대와 환경파괴의 최소화, 인간의 건강 증진을 목표로 삼는 비영리단체입니다. 비건 소사이어티(Vegan Society)는 긍정적인 삶과 환경을 위해 채식 실천을 선도하고 기부를 받지 않는 비영리 단체입니다. 마지막 PETA(People for the Ethical Treatment of Animals)는 미국에 기반한 세계적인 동물 권익 보호단체입니다. 'Beauty without Bunnies'라는 크루얼티 프리 인증으로 사회적인 책임을 다하는 브랜드인지 아닌지를 구분할 수 있게 하고 있습니다. 화장품 산업에 비건 인증은 동물 및 동물 유래 성분을 포함하지 않고, 제조 과정에서 동물 실험을 하지 않은 식물성 화장품에 부여하는 유기농 인증입니다. 유기농 화장품보다 더 엄격한 친환경 제품임을 드러낼 수 있습니다. 국내에서도 최초 비건 인증 기관인 '한국비건인증원'이 세워졌고, 식약처 허가와 식품 관련 인증 표시, 광고 가능하도록 지정했습니다.
 @grandviewresearch
@grandviewresearch그랜드뷰리서치에 따르면 미국 비건 화장품 시장은 연평균 6.3% 성장하고 있으며, 2025년에는 208억 달러(23조 2,800억 원)에 이를 것으로 전망하고 있습니다. 비건 화장품의 경우 비건 식생활에 비해 생산자와 소비자 모두 쉽게 접근하고 제품화할 수 있기에 성장률은 더 높아질 것 같습니다. 왜 비건 뷰티가 중요해졌을까요? 아무래도 반려동물 가구의 증가로 소비자들도 동물 복지에 대해서 고려하기 시작했습니다. 오랫동안 미국과 유럽 등 선진국에서는 "동물 윤리"가 중요한 키워드였는데 가치 소비 트렌드와 맞물려 의미가 더 커졌습니다. *소비자들은 화장품의 성분 이외에도 만드는 과정 자체에 관심을 갖기 시작했다는 점과 MZ세대가 가치 소비, 환경 윤리 미션에 동참하는 브랜드를 더 지지한다는 것도 기업들의 움직임에 영향을 준 것 같습니다.
*ref. 뉴스픽 : 요즘 2030이 선호하는 브랜드 BEST 10 (newspic.kr)
우리가 잘 아는 브랜드인 러쉬(Lush)에서는, 동물실험 금지하고 생산 제품의 80% 비건으로 만들고 있습니다. 신선한 과일과 야채, 에센셜 오일과 안전한 원료만 사용하는 것으로 알려져 있습니다. 특히 동물실험을 하지 않는 회사와 거래하는 것으로 유명합니다. 미국 유기농 화장품 닥터브로너스(drbronners)도 대표 비건 코스메틱 중 하나입니다. 닥터브로너스는 제품 생산 모든 과정에서 동물 실험을 하지 않았음을 증명하는 크루얼티 프리 인터내셔널 인증 마크인 리핑버니 인증을 받았습니다. 더 비건 글로우(theveganglow)는 비즈왁스나 동물성 글리세린, 달팽이 등 수많은 동물성 성분은 배제하고 100% 식물성 성분을 사용합니다. 독일 자연주의 화장품 브랜드 안네마리 보린(ANNEMARIE BÖRLIND)은 청정지역이라고 알려진 블랙 포레스트의 암반수와 자연 방식으로 얻은 식물성 추출물만을 사용하며 동물성 원료를 단 1%도 넣지 않은 제품만을 판매하고 있습니다. 동물실험과 동물성 원료 사용을 배제하고 식물 유래 성분만을 사용해 메이크업 아티스트들과 뷰티 유튜버들에게 사랑을 받고 있는 오프라 코스메틱(ofracosmetics), 색조화장품의 대표 비건 코스메틱 아워글래스(hourglasscosmetics)가 있습니다. 샹테카이(chantecaille)는 동물 실험은 일절 하지 않는 PETA의 크루얼티 프리 인증을 받아 할리우드 스타들이 애정하는 브랜드입니다. 이렇게 많은 브랜드들이 비건 코스매틱 시장을 주도하고 성장시키고 있습니다.
소개하고 싶은 브랜드는 미국 내추럴 비건 스킨케어 브랜드인 'meow meow tweet'입니다. 'Positively Natural Vegan SkinCare'를 태그라인으로 갖고 있습니다. 저온추출과 식물성 원료, 오가닉 오일 등 내추럴 원료 처방으로 만든 데오드란트, 훼이셜, 바디케어 전반에 걸친 라인을 갖고 있습니다. 'Less Plastic, biodegrable'의 패키지 기준을 가지고 키치한 감성의 네이밍과 트렌디한 패키징을 만들어 선보입니다. 또 패키지를 활용해 인테리어 소품으로 재활용하는 팁을 제공하기도 하고, DIY 마스크, DIY 데오드란트 워크숍 등 직접 오가닉 원료로 만들어 사용할 수 있도록 팁도 제공하고 있습니다. 환경과 동물 보호 등 비슷한 가치를 추구하는 단체 후원하고 있습니다.
전 세계 소비자들의 구매 선호도와 패턴이 사회와 환경에 미치는 영향에 대해 점점 더 인식하고 있습니다. 소비자들은 이제 제품 선택을 할 때 원료나 원산지, 제품 개발의 전 과정에 대해서 더 의식하고 주목합니다. 본질적으로 화장품 산업은 경쟁이 치열하며 원료나 포뮬러 등의 지속적인 혁신과 효과를 찾는 노력을 하는 산업군입니다. 환경에 대한 인식이 높아지면서 기존에 사용했던 원료나 제형을 구현하는 레시피, 패키징 등에서 동물 유래 원료를 피하고, 재활용 가능한 패키징으로 오염을 줄이는 노력을 해야 합니다. 지속 가능한 경영을 위한 연구 개발과 기업들의 노력은 앞으로 화장품 시장이 건강하게 성장하는데 도움이 될 것이라고 봅니다.
@ref.
- https://www.lushusa.com/discover/vegan/
- https://www.drbronner.com/?s=vegan
- https://theveganglow.com/#features
- https://www.boerlind.com/en-us/catalogsearch/result/?q=vegan
- https://www.ofracosmetics.com/
- https://www.hourglasscosmetics.com/collections/vegan-makeup
- https://chantecaille.com/collections/vegan
#화장품 #트렌드 #뷰티 #뷰티트렌드 #코스메틱 #비건 #프로바이오틱스 #비건뷰티 #비건라이프스타일 #오가닉 #스킨케어브랜드 #브랜드 #인식 #지속가능성